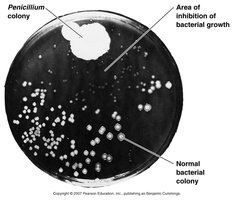
Penicillium on agar plate showing inhibition of bacterial growth
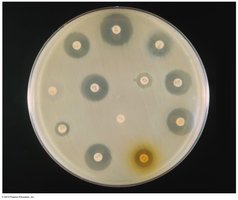
Diameter of zone of inhibition measured in disk diffusion test
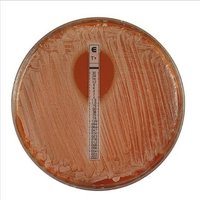
E Test showing MIC

BackAntimicrobial Drugs: Mechanisms, Classes, and Clinical Applications
Study Guide - Smart Notes
Tailored notes based on your materials, expanded with key definitions, examples, and context.
Antimicrobial Drugs: Introduction and Principles
Definition and Selective Toxicity
Antimicrobial drugs are agents used to treat infections by inhibiting or killing pathogenic microorganisms. The ideal antimicrobial drug exhibits selective toxicity, meaning it targets harmful microbes without damaging the host's cells.
Chemotherapy: Treatment of disease with chemicals taken into the body.
Antimicrobial drugs: Interfere with microbial growth within a host.
Antibiotic: Substance produced by a microbe that inhibits another microbe in small amounts.
Synthetic drugs: Chemically synthesized in the laboratory (e.g., sulfa drugs).
Antibiotics: Naturally produced by microorganisms such as Streptomyces, Bacillus, Penicillium, and Cephalosporium.
Historical Milestones
Paul Ehrlich: Developed the first chemotherapeutic agent, salvarsan, for syphilis.
Alexander Fleming: Discovered penicillin, the first true antibiotic, from Penicillium mold.
Criteria for Antimicrobial Drugs
Selective toxicity (toxic to microbes, not host)
Low or no hypersensitivity
Solubility in body fluids
Low potential for resistance development
The Spectrum of Antimicrobial Activity
Broad vs. Narrow Spectrum
The spectrum of activity refers to the range of microorganisms affected by a drug.
Broad-spectrum: Effective against a wide variety of microbes.
Narrow-spectrum: Effective against a limited group (e.g., Penicillin G targets mainly gram-positive bacteria).
Superinfection: Overgrowth of non-susceptible organisms during antibiotic therapy.

Microbial Sources of Antibiotics
Many antibiotics are derived from specific microorganisms.
Microorganism | Antibiotic |
|---|---|
Bacillus subtilis | Bacitracin |
Paenibacillus polymyxa | Polymyxin |
Streptomyces nodosus | Amphotericin B |
Streptomyces venezuelae | Chloramphenicol |
Streptomyces aureofaciens | Chlortetracycline, Tetracycline |
Saccharopolyspora erythraea | Erythromycin |
Streptomyces fradiae | Neomycin |
Streptomyces griseus | Streptomycin |
Micromonospora purpurea | Gentamicin |
Cephalosporium spp. | Cephalothin |
Penicillium griseofulvum | Griseofulvin |
Penicillium chrysogenum | Penicillin |

Mechanisms of Action of Antimicrobial Drugs
Bactericidal vs. Bacteriostatic
Bactericidal: Kill microbes directly.
Bacteriostatic: Inhibit growth, allowing host defenses to eliminate the pathogen.
Major Mechanisms
Inhibition of cell wall synthesis (e.g., penicillins, cephalosporins)
Inhibition of protein synthesis (e.g., chloramphenicol, tetracyclines, streptomycin)
Injury to plasma membrane (e.g., polymyxin B, amphotericin B)
Inhibition of nucleic acid synthesis (e.g., quinolones, rifampin)
Inhibition of essential metabolite synthesis (e.g., sulfonamides)

1. Inhibition of Cell Wall Synthesis
Drugs like penicillins and cephalosporins block peptidoglycan synthesis, leading to cell lysis. These drugs are most effective against actively growing bacteria and have selective toxicity because eukaryotic cells lack peptidoglycan.

2. Inhibition of Protein Synthesis
Antibiotics can bind to bacterial ribosomes (70S), which differ from eukaryotic ribosomes (80S), thus selectively inhibiting bacterial protein synthesis.
Chloramphenicol: Binds 50S subunit, inhibits peptide bond formation.
Streptomycin: Changes shape of 30S subunit, causes mRNA to be read incorrectly.
Tetracyclines: Interfere with tRNA attachment to the ribosome-mRNA complex.
Erythromycin: Binds 50S subunit, prevents translocation.

3. Injury to the Plasma Membrane
Some drugs disrupt membrane integrity, causing cell contents to leak out. Polymyxin B is effective against gram-negative bacteria, while amphotericin B and nystatin target fungal membranes by binding to sterols.

4. Inhibition of Nucleic Acid Synthesis
Drugs such as quinolones and rifampin interfere with DNA replication or transcription. Because microbial and human nucleic acids are similar, these drugs have limited selectivity and may have more side effects.
5. Inhibition of Synthesis of Essential Metabolites
Sulfonamides (sulfa drugs) are competitive inhibitors of enzymes involved in folic acid synthesis, a pathway present in bacteria but not in humans.

Classes and Examples of Antimicrobial Drugs
Inhibitors of Cell Wall Synthesis
Penicillins: Natural (Penicillin G, V), semisynthetic (oxacillin, ampicillin), extended-spectrum.
Cephalosporins: Four generations, increasing spectrum.
Polypeptide antibiotics: Bacitracin (topical), vancomycin (last line for MRSA).
Antimycobacterial antibiotics: Isoniazid and ethambutol (target mycolic acid in Mycobacterium cell walls).
Inhibitors of Protein Synthesis
Chloramphenicol: Broad spectrum, risk of gray baby syndrome.
Aminoglycosides: Streptomycin, neomycin, gentamicin (broad spectrum, change 30S subunit shape).
Tetracyclines: Broad spectrum, interfere with tRNA attachment, can chelate metal ions.
Macrolides: Erythromycin, azithromycin (bind 50S, block translocation).
Glycylcyclines: Bind 30S, inhibit translation (effective against MRSA).
Cycloheximide: Fungicide, binds 60S subunit, prevents polypeptide elongation.
Inhibitors of Nucleic Acid Synthesis
Rifamycins: Inhibit RNA synthesis (anti-tuberculosis).
Quinolones/Fluoroquinolones: Inhibit DNA gyrase (e.g., ciprofloxacin for UTIs).
Inhibitors of Essential Metabolite Synthesis
Sulfonamides: Inhibit folic acid synthesis, broad spectrum.
Antifungal Drugs
Polyenes (Amphotericin B): Bind membrane sterols, treat systemic mycoses, nephrotoxic.
Azoles (Miconazole, Triazole): Inhibit ergosterol synthesis, treat superficial mycoses.
Allylamines (Terbinafine): For azole-resistant infections.
Griseofulvin: Inhibits microtubule formation, treats dermatophytes.
Flucytosine: Cytosine analog, interferes with RNA synthesis.
Antiviral Drugs
Amantadine: Inhibits viral uncoating (influenza).
Acyclovir, Zidovudine: Inhibit nucleic acid synthesis (herpes, HIV).
Protease and Integrase inhibitors: Block HIV enzymes.
Entry and Fusion inhibitors: Block viral entry (HIV, influenza).
Interferons: Prevent spread of viruses to new cells.
Anti-protozoan and Anti-helminthic Drugs
Chloroquine, Artemisinin: Treat malaria.
Metronidazole: Interferes with anaerobic metabolism (protozoa, anaerobic bacteria).
Niclosamide, Praziquantel, Mebendazole, Albendazole, Ivermectin: Treat various helminthic infections by inhibiting ATP production, altering membrane permeability, or interfering with nutrient absorption.
Tests to Guide Chemotherapy
Susceptibility Testing
Kirby-Bauer Disk Diffusion: Measures zone of inhibition around antibiotic disks on agar plates. Results are interpreted as Sensitive, Resistant, or Intermediate.
Tube Dilution: Determines minimum inhibitory concentration (MIC) and minimum bactericidal concentration (MBC) by exposing bacteria to increasing drug concentrations.
E Test: Advanced method for direct MIC estimation using a gradient strip.
Antimicrobial Drug Resistance
Mechanisms of Resistance
Enzymatic breakdown of drug (e.g., penicillinase)
Prevention of drug penetration
Alteration of drug target site
Efflux of drug from the cell
Resistance genes are often carried on plasmids or transposons and can be transferred between bacteria by conjugation or transduction.
Factors Promoting Resistance
Misuse of antibiotics (e.g., incomplete regimens, use for viral infections, use in animal feed)
Effects of Drug Combinations
Synergism: Combined drugs have greater effect (e.g., penicillin + clavulanic acid).
Antagonism: Combined drugs have reduced effect (e.g., penicillin and tetracycline).

Side Effects of Antimicrobial Drugs
Opportunistic infections (e.g., oral thrush)
Drug-specific side effects (e.g., tetracycline staining teeth)
